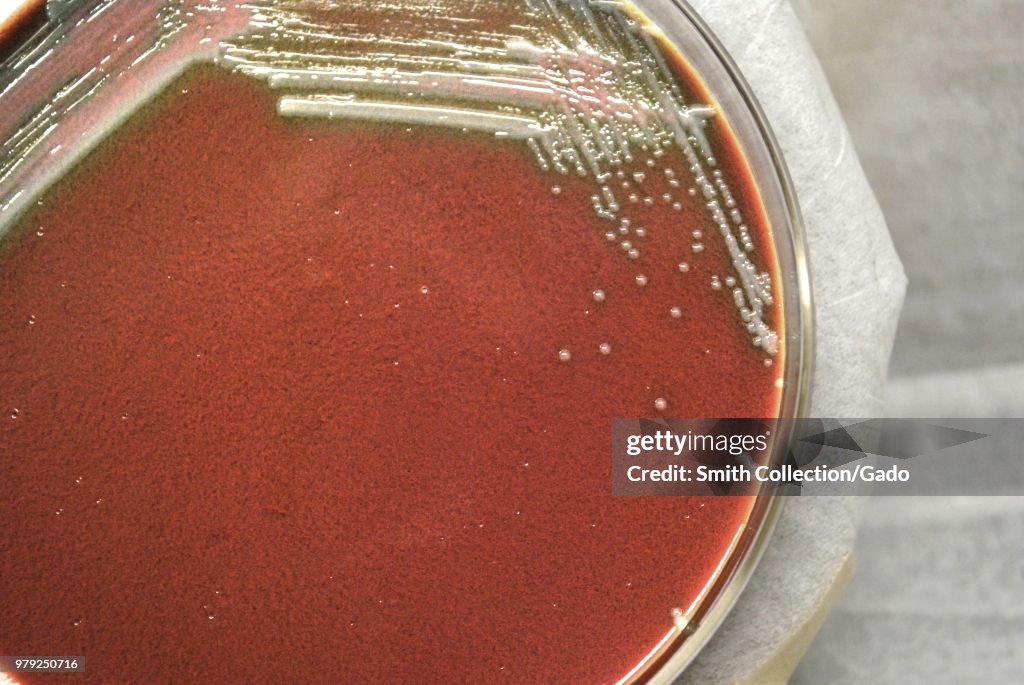

Francisella Tularensis
Colonial morphology of Gram-negative Francisella tularensis bacteria grown 48 hours on a medium of cysteine heart agar, 2010. Image courtesy Centers for Disease Control (CDC) / Dr Todd Parker, Audra Marsh. (Photo by Smith Collection/Gado/Getty Images)

PURCHASE A LICENSE
How can I use this image?
€300.00
EUR
Getty ImagesFrancisella Tularensis, News Photo Francisella Tularensis Get premium, high resolution news photos at Getty ImagesProduct #:979250716
Francisella Tularensis Get premium, high resolution news photos at Getty ImagesProduct #:979250716
Francisella Tularensis Get premium, high resolution news photos at Getty ImagesProduct #:979250716
Francisella Tularensis Get premium, high resolution news photos at Getty ImagesProduct #:979250716€475€115
Getty Images
In stockPlease note: images depicting historical events may contain themes, or have descriptions, that do not reflect current understanding. They are provided in a historical context. .
DETAILS
Restrictions:
Contact your local office for all commercial or promotional uses.
Credit:
Editorial #:
979250716
Collection:
Archive Photos
Date created:
January 01, 2010
Upload date:
License type:
Release info:
Not released.��More information
Source:
Archive Photos
Object name:
169809final.jpg
Max file size:
5300 x 3547 px (17.67 x 11.82 in) - 300 dpi - 8 MB